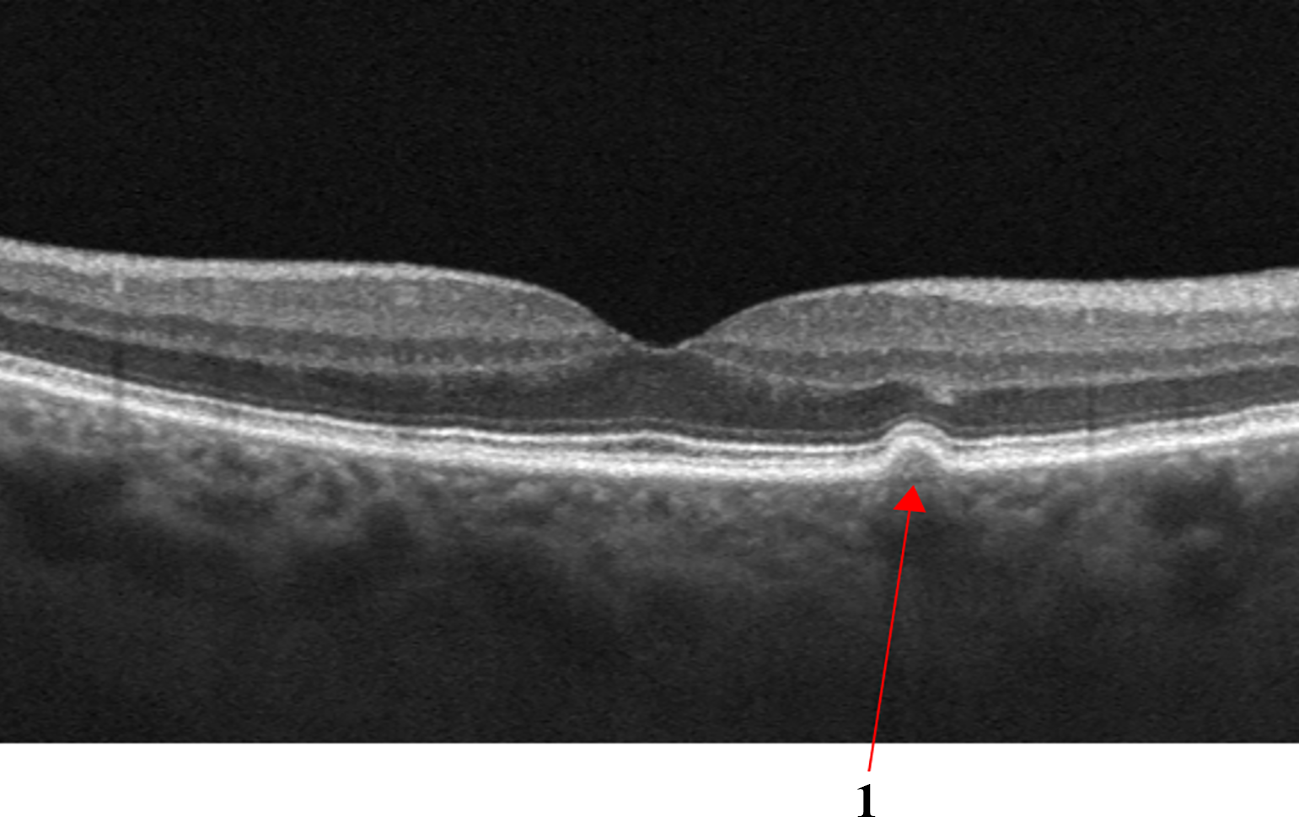
Refer to caption
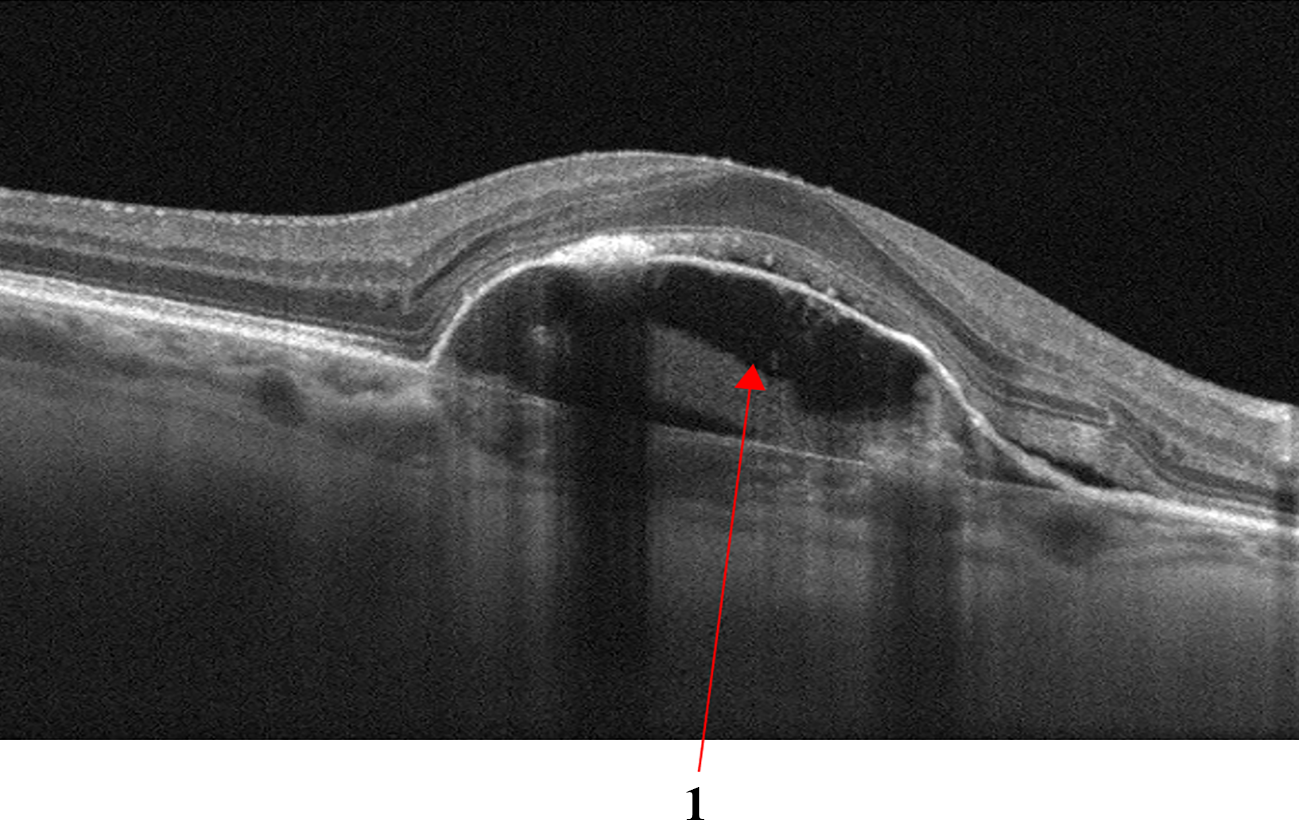
Refer to caption
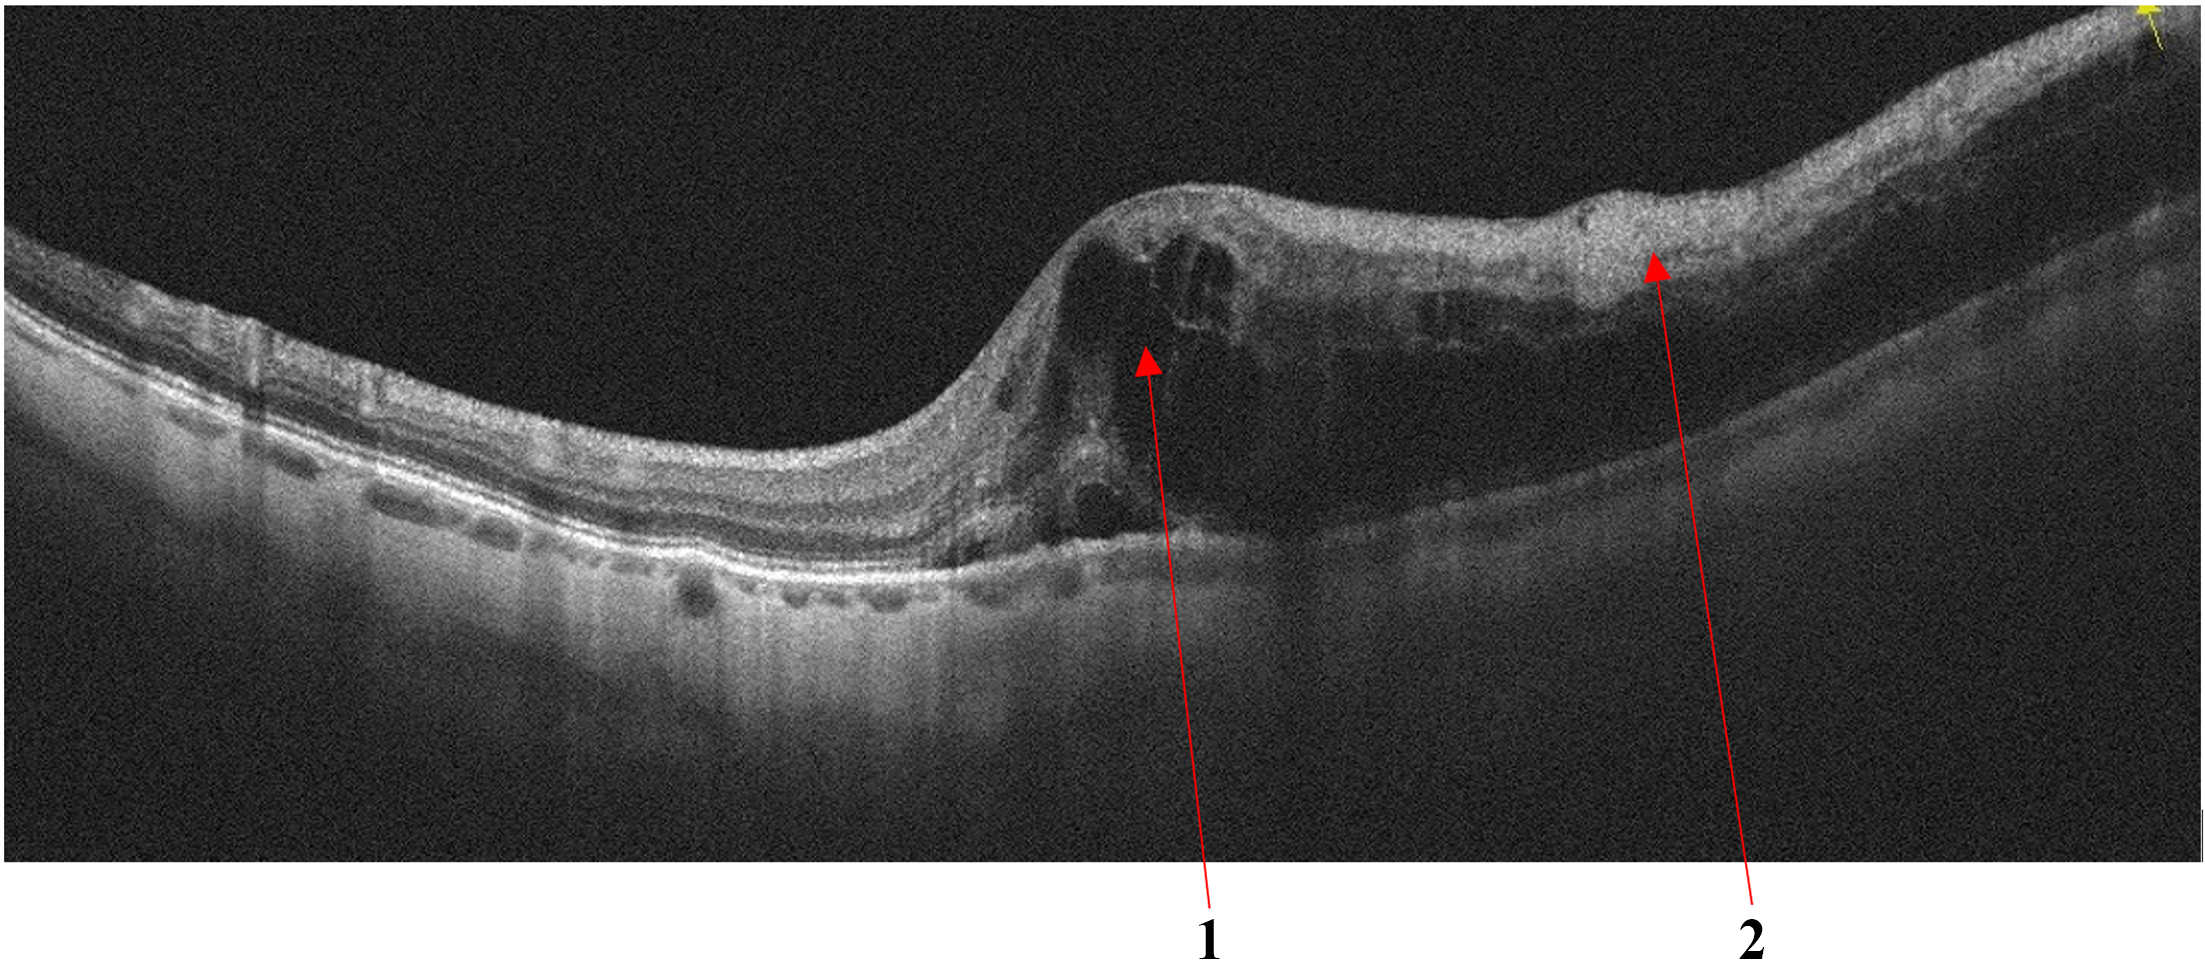
Refer to caption
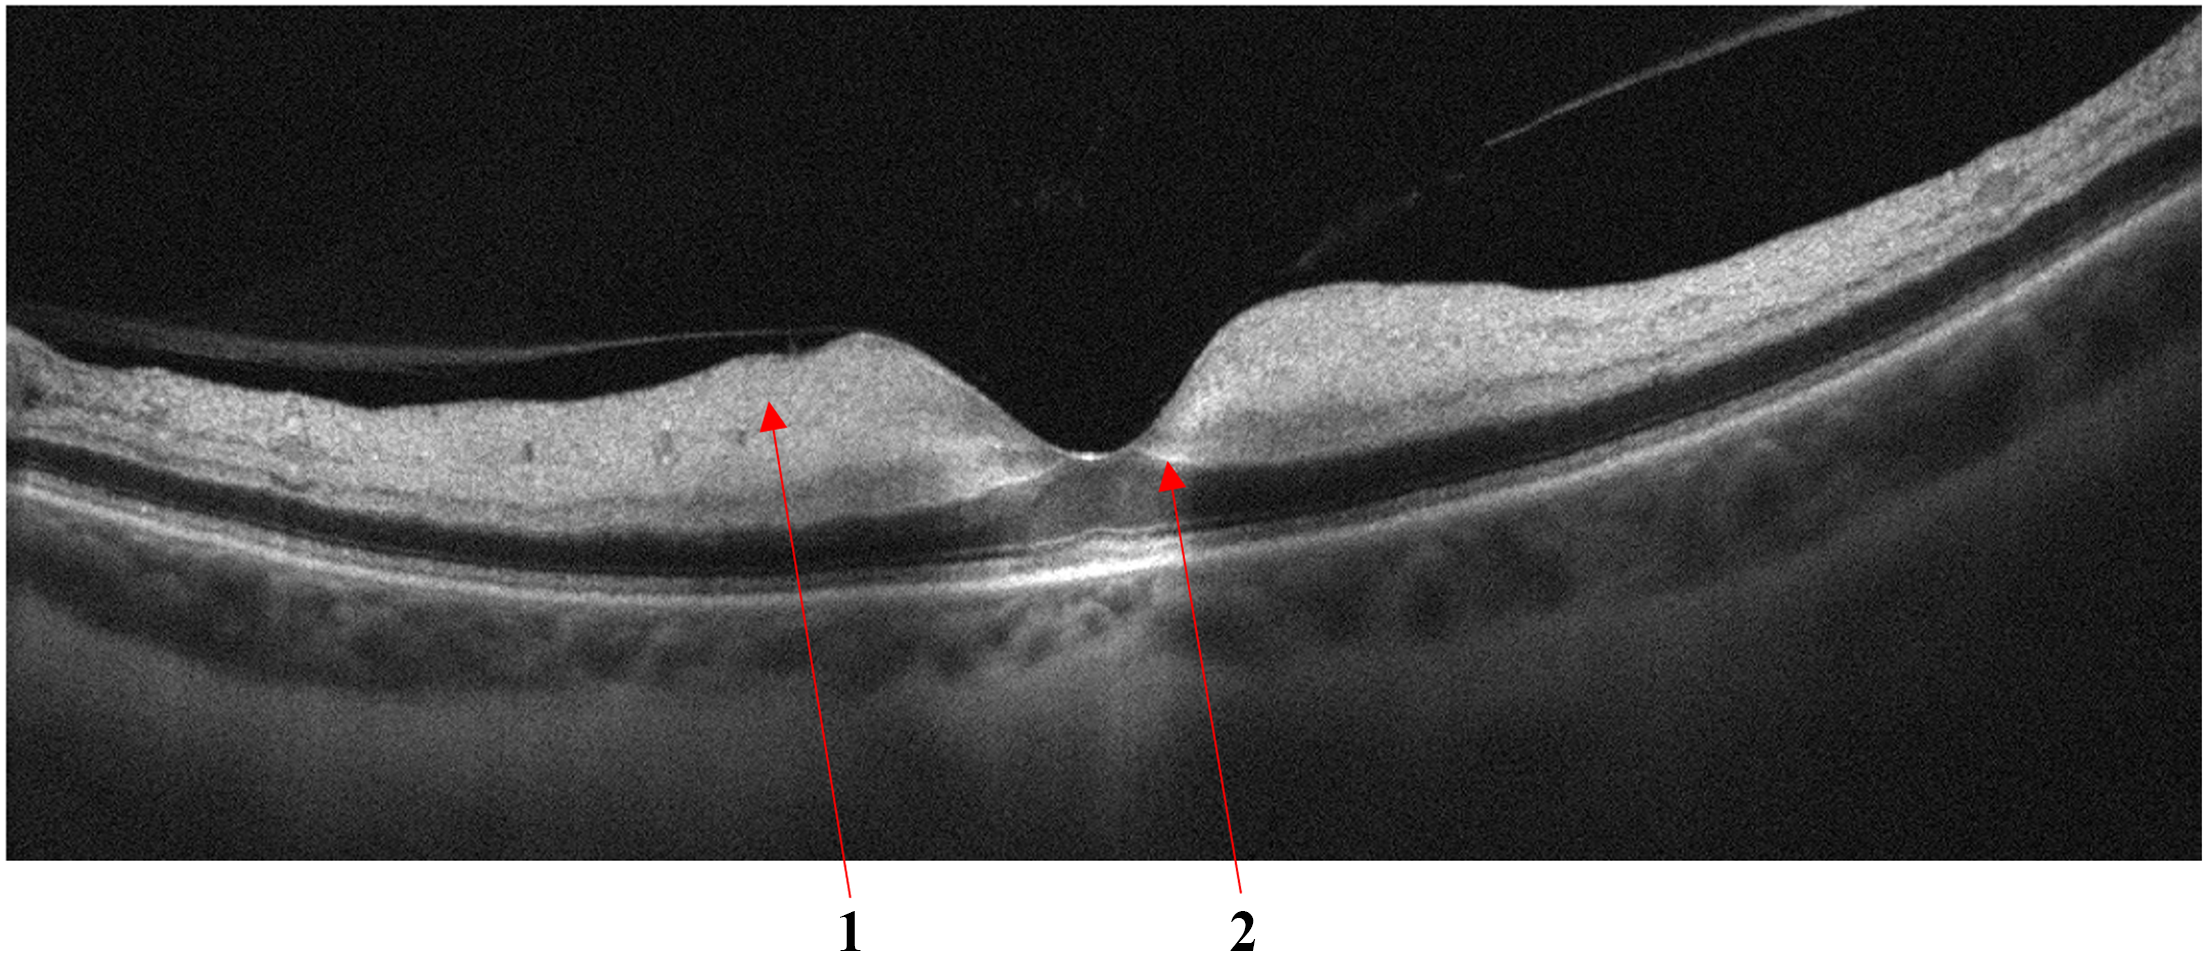
Refer to caption
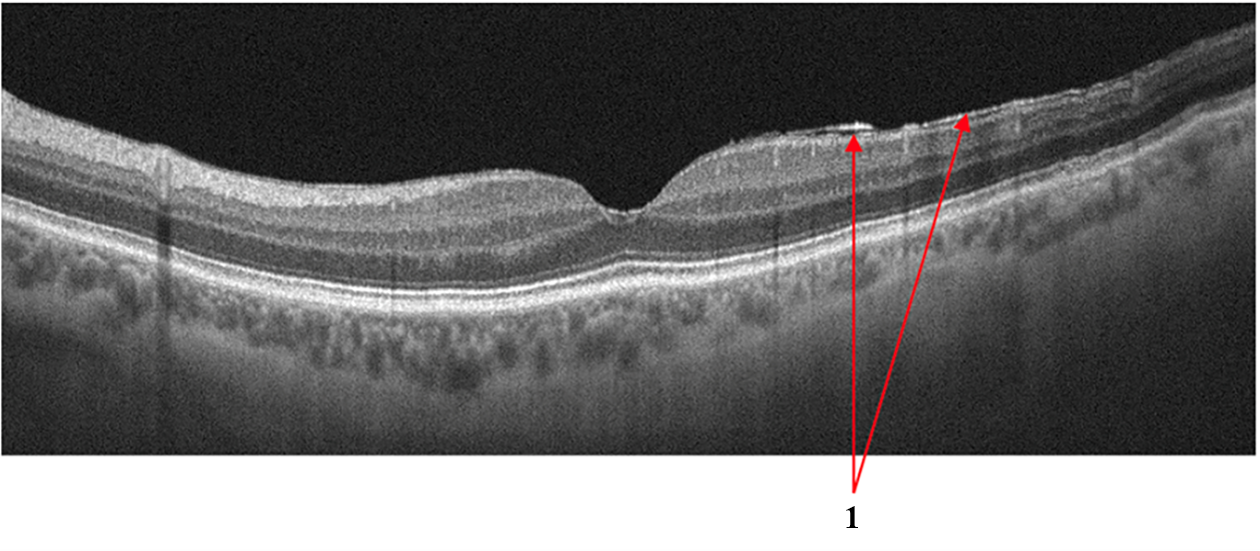
Refer to caption
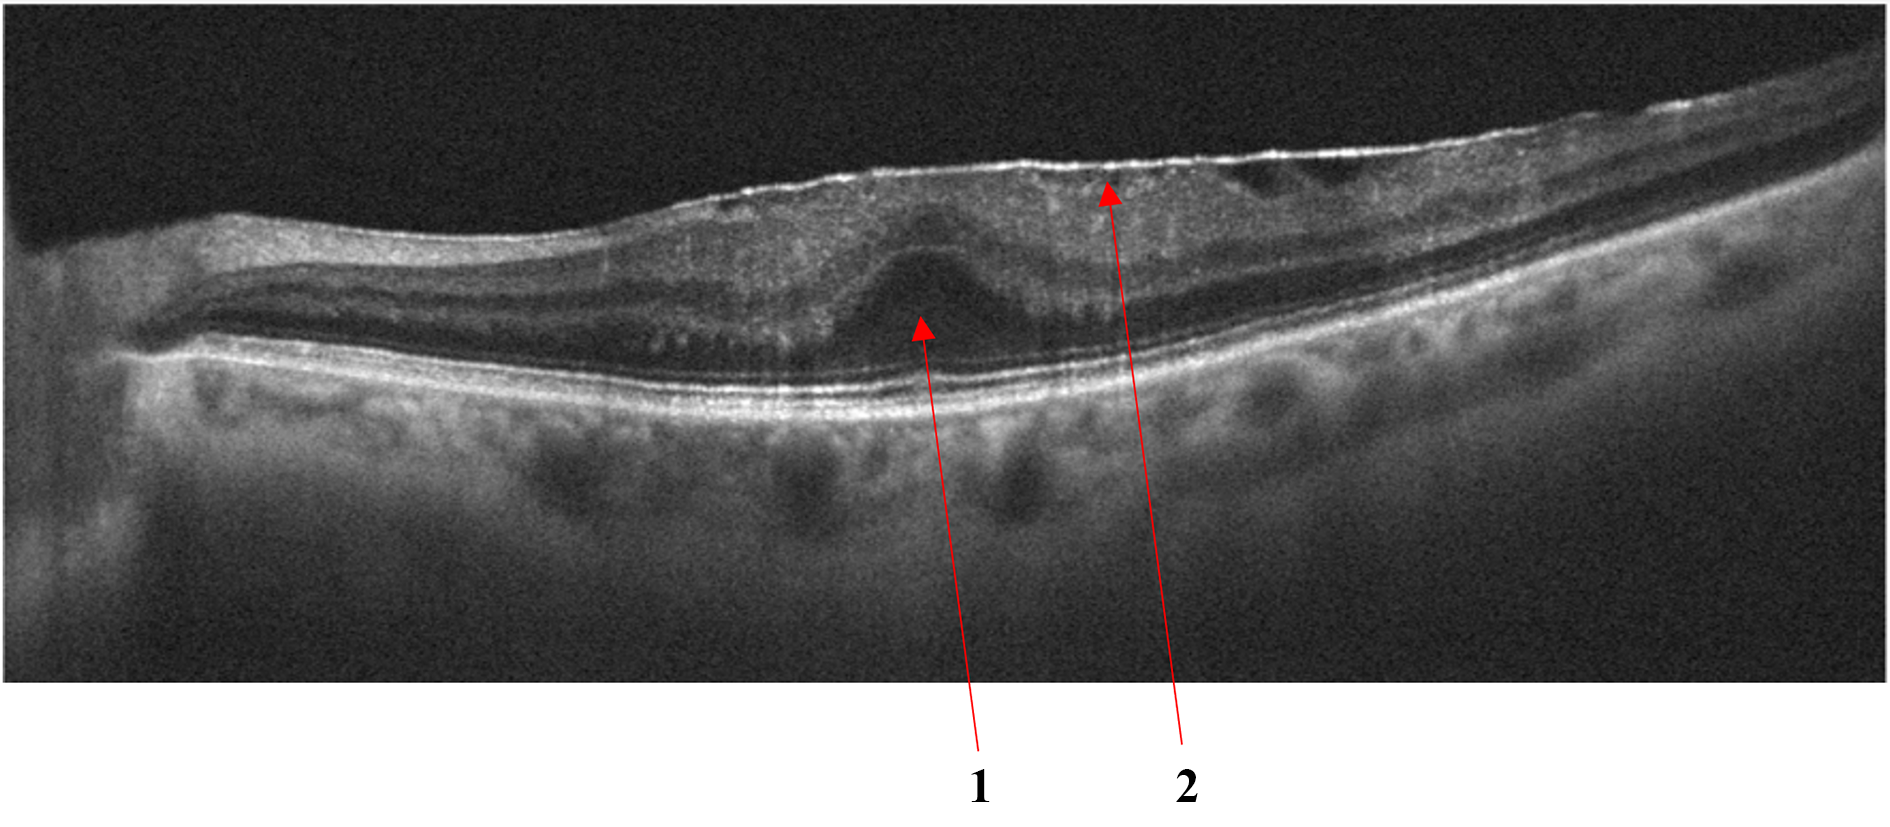
Refer to caption

OCTDL: Optical Coherence Tomography Dataset for Image-Based Deep Learning Methods
Abstract
Optical coherence tomography (OCT) is a non-invasive imaging technique with extensive clinical applications in ophthalmology. OCT enables the visualization of the retinal layers, playing a vital role in the early detection and monitoring of retinal diseases. OCT uses the principle of light wave interference to create detailed images of the retinal microstructures, making it a valuable tool for diagnosing ocular conditions. This work presents an open-access OCT dataset (OCTDL) comprising over 1600 high-resolution OCT images labeled according to disease group and retinal pathology. The dataset consists of OCT records of patients with Age-related Macular Degeneration (AMD), Diabetic Macular Edema (DME), Epiretinal Membrane (ERM), Retinal Artery Occlusion (RAO), Retinal Vein Occlusion (RVO), and Vitreomacular Interface Disease (VID). The images were acquired with an Optovue Avanti RTVue XR using raster scanning protocols with dynamic scan length and image resolution. Each retinal b-scan was acquired by centering on the fovea and interpreted and cataloged by an experienced retinal specialist. In this work, we applied Deep Learning classification techniques to this new open-access dataset.
Background & Summary
Optical coherence tomography (OCT) is a non-invasive imaging modality that is of great importance in clinical ophthalmology [1, 2]. OCT is one of the most widely used, rapidly developing medical imaging technologies. Today, visualization of the neural tissue is not limited to the macular area as it was at the beginning of OCT [3] but also to the vascular structures as well [4]. OCT imaging of the retina was first proposed by Huang et al. [5] in 1991. OCT utilizes the basic principle of low coherent light interferometry to detect the backscattered near-infrared light to reconstruct the depth profile of the biological tissue sample. The relatively low resolution of the first OCT devices has been gradually improved so that the image quality is now able to resolve more subtle changes in retinal morphology. Numerous studies have shown that OCT can be used in monitoring and confirming many common and sight-threatening ocular conditions, such as glaucoma [6], diabetic retinopathy [7], and age-related macular degeneration [8].
In this work, we present a new open-access OCT dataset for Image-Based Deep Learning Methods (OCTDL) comprising over 1600 high-resolution OCT images labeled according to various pathological conditions. The OCTDL dataset includes macular raster scans of Age-related Macular Degeneration (AMD), Diabetic Macular Edema (DME), Epiretinal Membrane (ERM), Retinal Artery Occlusion (RAO), Retinal Vein Occlusion (RVO), and Vitreomacular Interface Disease (VID) with the following pathological conditions: Macular Neovascular membranes (MNV), Disorganization of Retinal Inner Layers (DRIL), drusen, Macular Edema (ME), and Macular Hole (MH). We also analyzed OCT scans from existing public datasets and applied Deep Learning (DL) classification methods to these as well as to the OCTDL dataset and with combinations of the OCTDL dataset and publicly available datasets. Table 1 lists a comparative analysis of published OCT datasets: Kermany [9] dataset, published in 2019, remains the most extensive in terms of the number of OCT images. The second largest OCT image open-access dataset is provided in our new dataset, OCTDL, which is described in this work. The most represented diseases in the published datasets are AMD (more than ten times), DME (more than three times), and central serous chorioretinopathy (CSC) (more than three times). The most common equipment used for capturing OCT images was the Heidelberg Engineering Spectralis and Zeiss Cirrus systems, as these OCT systems provide high-resolution and wide-spectrum eye images for diagnosing various ocular conditions.
Open-access datasets
The RETOUCH [10] dataset was sourced from the retinal OCT fluid challenge of MICCAI 2017. This dataset features 70 OCT volumes labeled for retinal fluid types — intra-retinal fluid (IRF), sub-retinal fluid (SRF), and pigment epithelial detachment (PED), related to ME secondary to AMD and RVO. The training data incorporated varying volumes from different OCT systems (Cirrus, Triton, Spectralis) labeled for different types of fluid manually by experienced human graders. The B-scans were annotated at the Medical University of Vienna and Radboud University Medical Center. The RETOUCH dataset is widely utilized in multiple studies related to retinal fluid classification and segmentation [11].
The University of Minnesota (UMN) [12] dataset comprises 600 OCT B-scan images from exudative AMD subjects. Each subject’s data includes approximately 100 B-scans, with the most significant area containing fluid chosen for exporting. The dataset includes manual annotation of IRF, SRF, and PED regions, enabling validation of segmentation algorithms. Challenges include a large number of fluid regions, making segmentation a complex task.
The OPTIMA [13] dataset, derived from the MICCAI 2015 cyst segmentation challenge, provides 30 macular volumes collected from different ophthalmic OCT devices: Cirrus, Spectralis, Topcon, and Nidek. This dataset is primarily used for IRF segmentation and was annotated by experienced human graders. The dataset was split into training and testing subsets with the macular scans. The challenge with this dataset is the precise localization of IRF segmentation areas contained in the volumes obtained from different devices.
The Duke [14] dataset is a public dataset provided by Duke University, featuring 110 annotated OCT B-scans from patients with severe DME. The scans are annotated with eight retinal layer boundaries, aiding the training and testing of segmentation algorithms. Special attention was given to anonymity, enabling public access to the dataset.
The healthy controls multiple sclerosis (HCMS) [15] dataset, provided by the Johns Hopkins University, contains OCT scans of 35 subjects featuring both healthy and multiple sclerosis subjects. The scans are annotated to limited semantic fluid regions, with additional preprocessing required to validate segmentation performance.
The Kermany [9] dataset, with 207130 OCT B-scan images, was constructed to categorize conditions including choroidal neovascularization (CNV), DME, drusen, and normal. Annotations were done by tiered graders, enabling an extensive dataset for retinal fluid labels in maculopathies.
The open-access OCTID [16] dataset comprises more than 500 high-resolution OCT images categorized across distinct pathological conditions. The dataset encompasses normal, MH, AMD, Central Serous Retinopathy (CSR), and Diabetic Retinopathy (DR). The dataset images are from raster scans, with a 2mm scan length and a resolution of 512x1024 pixels. Moreover, 25 normal OCT images are supplemented with precise delineations for accurate OCT image segmentation evaluation. The dataset serves as a valuable resource for early diagnosis and monitoring of retinal diseases.
The OCTDL dataset, reported here, comprises 1618 images categorized into various diseases and eye conditions. These high-resolution OCT B-scans allow the visualization of the retinal layers centered on the fovea, the posterior vitreous body, and the choroidal vessels. This large open-access dataset is provided to aid in the diagnosing and monitoring of retinal diseases. The dataset was released for research and algorithm development, and it offers fully labeled images to advance automatic processing and early disease detection. Updates are planned for ongoing enhancement with additional clinical populations and samples.
| Year | Dataset | Dataset Size | Equipment Used | Labels | Access |
|---|---|---|---|---|---|
| 2015 | Duke [14] | 110 B-scan images | Not specified | Severe DME | open |
| 2016 | OPTIMA [13] | 30 volumes | Cirrus, Topcon | IRF | open |
| 2017 | Lee [17] | 1289 B-scan images | Spectralis | ME | limited |
| 2017 | UMN [12] | 600 B-scan images | Spectralis | Exudative AMD | open |
| 2018 | Kermany [9] | 207130 B-scan images | Spectralis | CNV, DME, Drusen, NO | open |
| 2018 | Schlegl [18] | 1200 B-scan volumes | Cirrus, Topcon | AMD, DME, RVO | limited |
| 2018 | OCTID [16] | 500 B-scan images | Not specified | MH, AMD, CSR, DR, NO | open |
| 2018 | Venhuizen [19] | 221 volumes | Spectralis | AMD | limited |
| 2019 | Hu [20] | 100 volumes | Not specified | SRF, PED | limited |
| 2019 | RETOUCH [10] | 70 volumes | Cirrus, Triton | AMD, RVO | open |
| 2019 | HCMS [15] | 35 volumes | Spectralis | Healthy Controls, MS | open |
| 2019 | Gao [21] | 52 volumes | Spectralis | CSC | limited |
| 2019 | Rao [22] | 150 volumes | Cirrus | Sub-retinal fluid segmentation | limited |
| 2020 | Yang [23] | 103 volumes | Cirrus | CSC | limited |
| 2020 | Bao [24] | 240 B-scan images | Not specified | AMD, PED | limited |
| 2021 | Pawan [25] | 25 volumes | Cirrus | CSC | limited |
| 2023 | OCTDL | 1618 B-scan images | Optovue Avanti | AMD, DME, ERM, NO, RAO, RVO, VID | open |
Limited access datasets
Schlegl et al. [18] dataset contains 1200 OCT B-scan volumes associated with AMD, DME, and Retinal Vein Occlusions, segmented by two experienced retinal specialists, to enable quantification of macular fluid in these conditions.
Gao et al. [21] provides 52 B-scan volumes that of Central Serous Chorioretinopathy (CSC). Their work introduced a deep learning model, double-branched and area-constraint fully convolutional networks (DA-FCN), which provides substantial high performance in segmenting subretinal fluid.
Lee et al. [17] dataset features 1289 B-scan images, which were provided to aid in the automated segmentation of ME using a convolutional neural network (CNN) to demonstrate high concordance between machine learning and expert human segmentation of the OCT scans.
Rao et al. [22] OCT dataset consists of 150 macular volumes for retinal fluid segmentation that were used to study the effects of signal noise and motion artifacts in segmenting sub-retinal fluid.
Yang et al. [23] dataset has 103 OCT volumes that were used for the automatic assessment of neurosensory retinal detachment and introduced the residual multiple pyramid pooling network (RMPPNet) to address segmentation challenges in Spectral Domain OCT images.
Bao et al. [24] dataset comprised 240 B-scans for PED segmentation. The attention multi-scale network (AM-Net) architecture was used to address the uneven sizes of PED and achieved accurate segmentation in the OCT-B scans.
Pawan et al. [25] dataset of 25 macular volumes aimed at segmenting SRF from central serous chorioretinopathy (CSCR) OCT images, and employed an enhanced SegCaps architecture, termed DRIP-Caps that provided an advanced alternative to existing models in segmentation of fluid in CSCR.
Hu et al. [20] dataset comprised 70 training, 15 testing, and 15 cases containing 126 scans each to segment SRF and PED lesions, using deep neural networks together with atrous spatial pyramid pooling (ASPP).
Venhuizen et al. [19] collected 221 OCT volumes (6158 B-scans) to segment intraretinal cystoid fluid (IRC) using a neural network cascade that significantly boosted performance by incorporating prior anatomical information.
Methods
The B-scan OCT images were acquired using a raster scanning protocol with dynamic scan length and image resolution and obtained with an Optovue Avanti RTVue XR. Each retinal scan was taken after centering the scan area over the macular fossa (fovea) and further interpreted and cataloged by an experienced retinal specialist. Axial and transverse resolutions were 5 m and 15 m, respectively. A superluminescent diode (SLD) with a wavelength of 840 nm served as the optical source. A beam of light directed toward the tissues forms an interference pattern with back-reflected light from the retina. This occurs due to the interaction of waves reflected from the tissue surface and waves that have traveled deep into the tissue. The back-reflected waves travel back to the beam splitter, where interference occurs. The interference fringes are detected by a detector that records the phase difference between the back-reflected waves. By measuring the difference in the time delay of interference fringes as a function of depth in the tissue, a 2D image of the internal structures of the retina is created. This method produces detailed, high-resolution images of the eye’s internal structures. Each image pixel’s light intensity corresponds to the wave reflected from a certain depth. Black-and-white images are formed based on different intensities of reflected light from various retina structures supra- and underlying tissues. Fig.1 shows an OCT image of a healthy normal retina of the fovea with retinal and choroidal structures. In Fig.1, dark areas (hyporeflective: 2, 8, 9, 16) may correspond to places where light is absorbed or scattered, and light (hyperreflective: 1, 3, 13, 14, 15) areas to places where back reflection occurs. Thus, black-and-white images visualize tissue structures and layers based on their optical properties and reflect differences in the intensity of light received from different depths.
The resulting images were marked by a practicing medical retina ophthalmologist. Labeling of the scans was made based on the retinal pathology and the patient’s clinical diagnosis.
The study was approved by the ethics committee of Ural Federal University Named after the First President of Russia B. N. Yeltsin (Conclusion No. 1, dated 1 February 2023). Informed consent was obtained from all subjects involved in the study.

Data records
The OCTDL dataset contains more than 1600 high-resolution images. All images are stored in JPG format in separate folders corresponding to the label. The name of each image consists of a shortcut of the corresponding disease and a sequence number. A separate CSV file stores the labels with classification by pathological conditions for all OCT scans. Table 2 shows the distribution of images in the dataset. Data was collected from more than 1000 patients aged 50 to 85 years, with a male-to-female ratio of 3:2 and mean age of 63 in Yekaterinburg, Russia. In this section, we provide a brief description of each of the disease groups.
| Disease | Label | Number of Image Scans |
|---|---|---|
| Age-related Macular Degeneration | AMD | 885 |
| Diabetic Macular Edema | DME | 143 |
| Epiretinal Membrane | ERM | 133 |
| Normal | NO | 284 |
| Retinal Artery Occlusion | RAO | 22 |
| Retinal Vein Occlusion | RVO | 93 |
| Vitreomacular Interface Disease | VID | 58 |
| Total | 1618 |
Age-related Macular Degeneration
AMD is an acquired retinal degeneration that causes significant central visual impairment resulting from a combination of non-neovascular (drusiform and abnormalities of the retinal pigment epithelium) and neovascular abnormalities (neovascular choroidal membrane formation). Disease progression may include focal areas of retinal pigment epithelium (RPE) loss, subretinal (sub-RPE) hemorrhages or serous fluid, and subretinal fibrosis [26]. Clinically, these late changes manifest with loss of central vision, ranging from low vision to blindness [27].
AMD is defined by specific changes in the macular, particularly the deposition of focal yellow extracellular deposits known as drusen 2a. On OCT, drusen appear as rounded mounds in the space between Bruch’s membrane and the basolateral membrane of the RPE and have a homogeneous reflectivity. Drusen are indicators of RPE stress and may be monitored for changes periodically by a medical retinal specialist [28].

As the disease progresses, the number of drusen becomes more extensive, and they tend to fuse and enlarge, becoming confluent. Cuticular drusen [29] are drusen that cluster at the macular region and have a characteristic saw tooth and double layer appearance on OCT (Fig.2b). One possible complication is drusenoid retinal pigment epithelium [30] (Fig.2c). Both conditions do not indicate starting treatment but require more frequent reviews and may require additional diagnostic methods to exclude the presence of any neovascularization in the choroid or sub-retinal space such as angiography.
Fig.3 shows examples of AMD: the retinal profile is deformed, and the normal foveal architecture is disrupted. In Fig.3a the inner retinal layers are thinned and contain outer retinal tubulations or cystic spaces, highlighted with number 1. Subfoveolarly, a hyporeflective region is visible beneath the retinal pigment epithelium - in Fig.3a highlighted with number 2. Hyperreflective coloration of the choriocapilaris below the RPE layer atrophy is apparent. Local and diffuse decreases in the thickness of the choriocapillaris layer. Fig.3b shows different fluid-filled spaces in the macular that may accompany the clinical features of AMD:
-
•
Subretinal fluid - space between the RPE and the neurosensory retina, in Fig.2b is shown with number 1.
-
•
Intraretinal fluid, a kind of hyperreflective cyst - a cyst in the inner retina, but the content differs in reflectivity - with a granular appearance indicating the presence of more reflective elements that may be cellular debris or protein that has leaked into the space, in Fig.2b is shown with number 2.
- •


Diabetic Macular Edema
DME is the most common cause of vision loss in patients with diabetic retinopathy, with an increasing prevalence associated with the global epidemic of type 2 diabetes mellitus [32, 33].
-
•
Hard exudates (HE) are defined as deposits of hyperreflective material replacing retinal tissue without increasing the underlying retinal thickness, and are considered an unfavorable sign representing the break down of the inner blood-retinal barrier with the potential to reduce visual acuity - in Fig.4a is shown with number 1.
-
•
Intraretinal fluid (IRF) appears as heterogeneous sized cavities with hyporeflective content due to their fluid content; slight retinal thickening may indicate initial changes of fluid accumulation with focal retinal edema that may precede the appearance of multiple cystic spaces - in Fig.4a is shown with number 2.


DRIL is an OCT biomarker, indicating poor definition of the boundaries of the inner retinal layers - in Fig.4b, DRIL is indicated by number 1. DRIL occurs in patients with various retinal vascular diseases with prolonged presence of intraretinal fluid, such as DME, or following a vascular occlusion, such as RVO. The degree of DRIL indicates the severity of the disease and correlates with the patient’s visual acuity prognosis. DRIL may persist even after the resolution of edema following treatment or in advanced stages of the disease [34].
Retinal Vein Occlusion
Secondary ME is the leading cause of visual loss in patients with central retinal vein occlusion (CRVO). OCT is the critical imaging modality to diagnose and formulate a treatment plan for cystic macular edema (CME) of this etiology. In contrast to DME, the ME secondary to a branch or CRVO is generally cystic and localized to the inner retina following leakage from engorged veins, Fig.5a. OCT scans also show a higher level of hyperreflectivity of the inner retina due to ischemia. The long-term prognosis of vein occlusion will depend on the degree of ischaemic damage to the retinal tissue and the structural damage to the neural pathways after CME resorption. The presence and severity of any DRIL is an indicator of likely visual prognosis [35, 36].

Retinal Artery Occlusion
Occlusion of the central retinal artery (CRAO) and its branches (BRAO) leads to the formation of acute tissue ischemia, giving a specific OCT picture - pronounced hyperreflectivity, loss of homogeneity, and edema of the inner parts of the retina containing the ganglion cells, Fig.5b. Also, a biomarker of acute ischemia is a prominent middle limiting membrane (p-MLM) - a hyperreflective line or band located in the inner part of the outer plexiform layer at the border with the outer nuclear layer. It is not ordinarily visible, which appears in the early period of the pathological damage and is due to opacification of the middle retinal layers [37].
Vitreomacular Interface Disease
VID is a term used to describe a group of diseases resulting from the pathologic course of the normal age-associated process of a posterior vitreous detachment. Usually, the process is completed without retinal deformation. However, vitreo-retinal traction occurs in cases of adhesion between the retina and vitreous body, which can lead to macular tears, cysts, or holes developing [38].
-
•
When pathologic adhesion of the posterior hyaloid to the retinal interface forms, progressive posterior vitreous detachment causes axial traction of the inner limiting membrane, formed by Müller cell end feet that deforms the retinal tissue, Fig.6a.
- •
-
•
One of the variants of MH with preservation of the integrity of the photoreceptor layer is a lamellar tear of the neurosensory retina, Fig.6c. The condition is often asymptomatic and requires no treatment, but regular monitoring by a medical retina specialist is advised.



Epiretinal Membrane
ERM can develop idiopathically, secondary to intraocular surgery or inflammation, and are characterized by the proliferation of glial tissue on the retina’s inner surface in the macular area, Fig.7a. The Pathologic connective tissue overgrowth results in epiretinal fibrosis (fibrosis of the inner border membrane, epiretinal membrane). Clinically, the disease is characterized by thickening and wrinkling of the inner limiting membrane, sometimes called cellophane retinopathy, because of its appearance on fundus examination[40].

In epiretinal membrane maturation, the vireo-retinal traction can deform the retina, reducing visual acuity, cause metamorphopsia, and can lead to macular tears and holes. In such cases, there is an irreversible loss of visual function without timely surgical intervention requiring an epiretinal membrane peel[41].
Technical Validation
In this work, we tested the performance of the DL architectures VGG16 [42] and ResNet50 [43] on our dataset (OCTDL). VGG16 and ResNet50 are well-established and widely recognized convolutional neural networks (CNN). They have been extensively studied and benchmarked on various OCT datasets [44, 45, 46]. Therefore, We can establish a strong baseline for the OCTDL dataset’s performance using these architectures. VGG and ResNet are considered classical architectures. However, they still perform remarkably well on many image classification problems [47, 48, 49].
VGG16 is a 16-layer, relatively extensive DL network with 138 million parameters. However, the simplicity of the VGG16 architecture is its main attraction. VGG16 has 13 convolutional layers and three fully connected layers, each followed by a ReLU activation function, five max pooling operations, and a softmax activation function.
ResNet was based on the VGG neural networks. However, a ResNet has fewer filters and is less complex than a VGG. Using shortcut connections, ResNet provided a novel way to use more convolutional layers without running into the vanishing gradient problem [50]. A shortcut connection skips some layers, converting a regular network to a residual network. The ResNet50 is a 50-layer CNN that consists of 48 convolutional layers, one MaxPool layer, and one average pool layer.
The OCTDL dataset was randomly split into training, validation, and test subsets in the proportion of 70:10:20, with all classes performed in all subsets. For all experiments, we used the Cross-Entropy loss function and Adaptive Moment Estimation (ADAM) optimizer with a 0.0005 learning rate. For data augmentation, we used random crop, horizontal and vertical flips, rotation, translation, and Gaussian blur.
The OCTDL dataset contains a file with labels for each image, which can be used to navigate from the disease to the corresponding pathological condition(s). This is necessary, for example, to combine different available datasets. Thus, for experiments, we combined OCTDL with OCTID and Kermany datasets. DME is a particular case of DR, and MH is a particular case of VID, so we can combine them into one category for classification purposes. Drusen and MNV are the early and late stages of AMD, respectfully. OCTDL and OCTID datasets were mixed and randomly split into subsets. For Kermany, we used OCTDL as a test subset.
The following presents the results of training neural networks exclusively on our dataset and combining our dataset with the OCTID and Kermany datasets to solve the classification problem. Confusion matrices for training on ResNet50 and VGG16 with our proposed dataset are presented in Fig.8. As metrics, we used Accuracy (ACC), F1 score, Area Under the Curve (AUC), Precision (P), and Recall (R). Table 3 summarizes the results of the experiments.


| Model | Dataset | Labels | ACC | F1 | AUC | P | R |
|---|---|---|---|---|---|---|---|
| ResNet50 | OCTDL | AMD, DME, ERM, NO, RAO, RVO, VID | 0.891 | 0.891 | 0.985 | 0.895 | 0.891 |
| VGG16 | OCTDL | AMD, DME, ERM, NO, RAO, RVO, VID | 0.895 | 0.895 | 0.980 | 0.896 | 0.895 |
| ResNet50 | OCTID | AMD, CSR, DR, MH, NO | 0.923 | 0.927 | 0.979 | 0.932 | 0.923 |
| VGG16 | OCTID | AMD, CSR, DR, MH, NO | 0.932 | 0.933 | 0.970 | 0.939 | 0.932 |
| ResNet50 | Kermany | CNV, DME, Drusen, NO | 0.998 | 0.998 | 0.999 | 0.998 | 0.998 |
| VGG16 | Kermany | CNV, DME, Drusen, NO | 0.998 | 0.998 | 0.999 | 0.998 | 0.998 |
| ResNet50 | OCTID + OCTDL | AMD, DR, MH, NO | 0.957 | 0.955 | 0.996 | 0.954 | 0.957 |
| VGG16 | OCTID + OCTDL | AMD, DR, MH, NO | 0.975 | 0.977 | 0.998 | 0.979 | 0.975 |
| ResNet50 | Kermany + OCTDL | CNV, DME, Drusen, NO | 0.833 | 0.805 | 0.963 | 0.823 | 0.833 |
| VGG16 | Kermany + OCTDL | CNV, DME, Drusen, NO | 0.818 | 0.798 | 0.966 | 0.823 | 0.818 |
The class-wise balanced accuracy across all categories within our dataset approached 0.9, with the highest accuracy observed for AMD at 0.963 and the lowest for RVO at 0.885. Similarly, the class-wise recall demonstrated a comparable pattern, with AMD exhibiting the highest value at 0.966 and RVO displaying the weakest at 0.789. These notably high metrics, even for categories with a relatively low number of image samples, suggest that the selection of image classes is appropriate and the images exhibit robust features. Concatenation of multiple datasets yielded favorable outcomes: this approach augmented the variety of diseases within open datasets and enabled the training of neural networks using images acquired from different OCT systems. This strategy holds the potential to bolster long-term reliability and enhance overall classification accuracy.
Further potential applications of the OCTDL dataset include the automated segmentation of OCT image layers, for which manual segmentation will also be performed. Labels with pathological conditions are also available in the OCTDL dataset for every image. Training on both disease and pathological condition labels with further voting ensembles could also increase classification accuracy. Semi- and Unsupervised anomaly detection [51] has also been tested for some diseases and is a promising direction for developing Artificial Intelligence (AI) in OCT.
The results show that the new OCTDL dataset may be used to support and expand the application of AI in ophthalmology [52]. The dataset will be extended and will become more balanced with respect to rare conditions, including inherited retinal dystrophies and retinopathy of prematurity that may assist with diagnosing and managing these and related sight-threatening conditions [53].
Data availability
The datasets used in this study are open-access, with our dataset available at https://zenodo.org/doi/10.5281/zenodo.10370472,
and https://data.mendeley.com/datasets/sncdhf53xc/1,
Kermany[9] dataset available at https://data.mendeley.com/datasets/rscbjbr9sj/3,
OCTID[16] dataset available at https://www.openicpsr.org/openicpsr/project/108503/version/V1/view.
Code availability
The code used to generate the results in this paper is available at https://github.com/MikhailKulyabin/OCTDL.
References
- [1] Duker, J. S., Waheed, N. K. & Goldman, D. Handbook of Retinal OCT: Optical Coherence Tomography E-Book (Elsevier Health Sciences, 2021).
- [2] Zhang, L., Van Dijk, E. H., Borrelli, E., Fragiotta, S. & Breazzano, M. P. Oct and oct angiography update: Clinical application to age-related macular degeneration, central serous chorioretinopathy, macular telangiectasia, and diabetic retinopathy. \JournalTitleDiagnostics 13, 232 (2023).
- [3] Lumbroso, B. & Rispoli, M. Practical handbook of OCT (JP Medical Ltd, 2012).
- [4] Coffey, A. M. et al. Optical coherence tomography angiography in primary eye care. \JournalTitleClinical and Experimental Optometry 104, 3–13 (2021).
- [5] Huang, D. et al. Optical coherence tomography. \JournalTitlescience 254, 1178–1181 (1991).
- [6] Geevarghese, A., Wollstein, G., Ishikawa, H. & Schuman, J. S. Optical coherence tomography and glaucoma. \JournalTitleAnnual review of vision science 7, 693–726 (2021).
- [7] Amoaku, W. M. et al. Diabetic retinopathy and diabetic macular oedema pathways and management: Uk consensus working group. \JournalTitleEye 34, 1–51 (2020).
- [8] Flores, R., Carneiro, Â., Tenreiro, S. & Seabra, M. C. Retinal progression biomarkers of early and intermediate age-related macular degeneration. \JournalTitleLife 12, 36 (2021).
- [9] Kermany, D. S. et al. Identifying medical diagnoses and treatable diseases by image-based deep learning. \JournalTitlecell 172, 1122–1131 (2018).
- [10] Bogunović, H. et al. Retouch: The retinal oct fluid detection and segmentation benchmark and challenge. \JournalTitleIEEE transactions on medical imaging 38, 1858–1874 (2019).
- [11] Rasti, R., Biglari, A., Rezapourian, M., Yang, Z. & Farsiu, S. Retifluidnet: A self-adaptive and multi-attention deep convolutional network for retinal oct fluid segmentation. \JournalTitleIEEE Transactions on Medical Imaging (2022).
- [12] Rashno, A. et al. Fully automated segmentation of fluid/cyst regions in optical coherence tomography images with diabetic macular edema using neutrosophic sets and graph algorithms. \JournalTitleIEEE Transactions on Biomedical Engineering 65, 989–1001 (2017).
- [13] Wu, J. et al. Multivendor spectral-domain optical coherence tomography dataset, observer annotation performance evaluation, and standardized evaluation framework for intraretinal cystoid fluid segmentation. \JournalTitleJournal of Ophthalmology 2016 (2016).
- [14] Chiu, S. J. et al. Kernel regression based segmentation of optical coherence tomography images with diabetic macular edema. \JournalTitleBiomedical optics express 6, 1172–1194 (2015).
- [15] He, Y. et al. Retinal layer parcellation of optical coherence tomography images: Data resource for multiple sclerosis and healthy controls. \JournalTitleData in brief 22, 601–604 (2019).
- [16] Gholami, P., Roy, P., Parthasarathy, M. K. & Lakshminarayanan, V. Octid: Optical coherence tomography image database. \JournalTitleComputers & Electrical Engineering 81, 106532 (2020).
- [17] Lee, C. S. et al. Deep-learning based, automated segmentation of macular edema in optical coherence tomography. \JournalTitleBiomedical optics express 8, 3440–3448 (2017).
- [18] Schlegl, T. et al. Fully automated detection and quantification of macular fluid in oct using deep learning. \JournalTitleOphthalmology 125, 549–558 (2018).
- [19] Venhuizen, F. G. et al. Deep learning approach for the detection and quantification of intraretinal cystoid fluid in multivendor optical coherence tomography. \JournalTitleBiomedical optics express 9, 1545–1569 (2018).
- [20] Hu, J., Chen, Y. & Yi, Z. Automated segmentation of macular edema in oct using deep neural networks. \JournalTitleMedical image analysis 55, 216–227 (2019).
- [21] Gao, K. et al. Double-branched and area-constraint fully convolutional networks for automated serous retinal detachment segmentation in sd-oct images. \JournalTitleComputer methods and programs in biomedicine 176, 69–80 (2019).
- [22] Rao, T. N., Girish, G., Kothari, A. R. & Rajan, J. Deep learning based sub-retinal fluid segmentation in central serous chorioretinopathy optical coherence tomography scans. In 2019 41st Annual International Conference of the IEEE Engineering in Medicine and Biology Society (EMBC), 978–981 (IEEE, 2019).
- [23] Yang, J. et al. Rmppnet: residual multiple pyramid pooling network for subretinal fluid segmentation in sd-oct images. \JournalTitleOSA Continuum 3, 1751–1769 (2020).
- [24] Bao, D., Cheng, X., Zhu, W., Shi, F. & Chen, X. Attention multi-scale network for pigment epithelial detachment segmentation in oct images. In Medical Imaging 2020: Image Processing, vol. 11313, 793–798 (SPIE, 2020).
- [25] Pawan, S. et al. Capsule network–based architectures for the segmentation of sub-retinal serous fluid in optical coherence tomography images of central serous chorioretinopathy. \JournalTitleMedical & Biological Engineering & Computing 59, 1245–1259 (2021).
- [26] Pandit, S. A. et al. Real-world outcomes of faricimab in patients with previously treated neovascular age-related macular degeneration. \JournalTitleOphthalmology Retina (2023).
- [27] Thomas, C. J., Mirza, R. G. & Gill, M. K. Age-related macular degeneration. \JournalTitleMedical Clinics 105, 473–491 (2021).
- [28] Han, X. et al. A systematic review of clinical practice guidelines for age-related macular degeneration. \JournalTitleOphthalmic Epidemiology 30, 213–220 (2023).
- [29] Fragiotta, S., Fernández-Avellaneda, P., Breazzano, M. P. & Scuderi, G. Clinical manifestations of cuticular drusen: current perspectives. \JournalTitleClinical Ophthalmology 3877–3887 (2021).
- [30] Shijo, T. et al. Incidence and risk of advanced age-related macular degeneration in eyes with drusenoid pigment epithelial detachment. \JournalTitleScientific Reports 12, 4715 (2022).
- [31] Wimmers, S., Karl, M. O. & Strauss, O. Ion channels in the rpe. \JournalTitleProgress in retinal and eye research 26, 263–301 (2007).
- [32] Browning, D. J., Stewart, M. W. & Lee, C. Diabetic macular edema: evidence-based management. \JournalTitleIndian journal of ophthalmology 66, 1736 (2018).
- [33] Huang, H., Jansonius, N. M., Chen, H. & Los, L. I. Hyperreflective dots on oct as a predictor of treatment outcome in diabetic macular edema: a systematic review. \JournalTitleOphthalmology Retina 6, 814–827 (2022).
- [34] Suciu, C.-I., Suciu, V.-I., Nicoara, S.-D. et al. Optical coherence tomography (angiography) biomarkers in the assessment and monitoring of diabetic macular edema. \JournalTitleJournal of Diabetes Research 2020 (2020).
- [35] Ciulla, T. A. et al. Anatomic biomarkers of macular edema associated with retinal vein occlusion. \JournalTitleOphthalmology Retina 6, 1206–1220 (2022).
- [36] Sen, P. et al. Predictors of visual acuity outcomes after anti–vascular endothelial growth factor treatment for macular edema secondary to central retinal vein occlusion. \JournalTitleOphthalmology Retina 5, 1115–1124 (2021).
- [37] Mangla, R. et al. Retinal oct findings in acute central retinal artery occlusion of varying severity at different disease stages–a retrospective, observational study. \JournalTitleInternational Journal of Retina and Vitreous 9, 1–10 (2023).
- [38] Duker, J. S. et al. The international vitreomacular traction study group classification of vitreomacular adhesion, traction, and macular hole. \JournalTitleOphthalmology 120, 2611–2619 (2013).
- [39] Rossi, T. et al. Macular hole closure patterns: an updated classification. \JournalTitleGraefe’s Archive for Clinical and Experimental Ophthalmology 258, 2629–2638 (2020).
- [40] Alkabes, M. et al. Correlation between new oct parameters and metamorphopsia in advanced stages of epiretinal membranes. \JournalTitleActa Ophthalmologica 98, 780–786 (2020).
- [41] Chua, P. Y., Sandinha, M. T. & Steel, D. H. Idiopathic epiretinal membrane: progression and timing of surgery. \JournalTitleEye 36, 495–503 (2022).
- [42] Simonyan, K. & Zisserman, A. Very deep convolutional networks for large-scale image recognition. \JournalTitlearXiv 1409.1556 (2014).
- [43] He, K., Zhang, X., Ren, S. & Sun, J. Deep residual learning for image recognition. In 2016 IEEE Conference on Computer Vision and Pattern Recognition (CVPR), 770–778, 10.1109/CVPR.2016.90 (2016).
- [44] Subramanian, M., Shanmugavadivel, K., Naren, O. S., Premkumar, K. & Rankish, K. Classification of retinal oct images using deep learning. In 2022 International Conference on Computer Communication and Informatics (ICCCI), 1–7 (IEEE, 2022).
- [45] Leandro, I. et al. Oct-based deep-learning models for the identification of retinal key signs. \JournalTitleScientific Reports 13, 14628 (2023).
- [46] Wang, J. et al. Deep learning for quality assessment of retinal oct images. \JournalTitleBiomedical optics express 10, 6057–6072 (2019).
- [47] Xu, G. et al. A deep transfer convolutional neural network framework for eeg signal classification. \JournalTitleIEEE Access 7, 112767–112776, 10.1109/ACCESS.2019.2930958 (2019).
- [48] Wu, Q.-e., Yu, Y. & Zhang, X. A skin cancer classification method based on discrete wavelet down-sampling feature reconstruction. \JournalTitleElectronics 12, 10.3390/electronics12092103 (2023).
- [49] Huang, G.-H. et al. Deep transfer learning for the multilabel classification of chest x-ray images. \JournalTitleDiagnostics 12, 10.3390/diagnostics12061457 (2022).
- [50] Hochreiter, S. The vanishing gradient problem during learning recurrent neural nets and problem solutions. \JournalTitleInternational Journal of Uncertainty, Fuzziness and Knowledge-Based Systems 6, 107–116 (1998).
- [51] Mou, L., Liang, L., Gao, Z. & Wang, X. A multi-scale anomaly detection framework for retinal oct images based on the bayesian neural network. \JournalTitleBiomedical Signal Processing and Control 75, 103619, https://doi.org/10.1016/j.bspc.2022.103619 (2022).
- [52] Kapoor, R., Walters, S. P. & Al-Aswad, L. A. The current state of artificial intelligence in ophthalmology. \JournalTitleSurvey of ophthalmology 64, 233–240 (2019).
- [53] Daich Varela, M. et al. Artificial intelligence in retinal disease: clinical application, challenges, and future directions. \JournalTitleGraefe’s Archive for Clinical and Experimental Ophthalmology 1–15 (2023).
Author contributions statement
Data collection, A.N., A.S., A.K.; conceptualization, M.K., A.Z. and A.N.; software, M.K.; writing-original draft preparation, M.K., A.N., V.B. and M.R.; writing—review and editing, V.B, M.R. and P.C; supervision, A.M., S.K., A.B. All authors have read and agreed to the published version of the manuscript.
Competing interests
The authors declare that they have no known competing financial interests or personal relationships that could have appeared to influence the work reported in this paper.